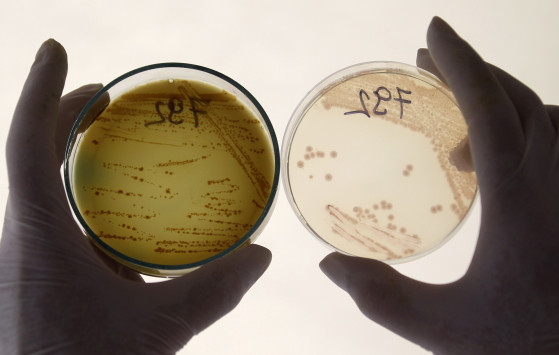

Πρόκειται για ένα από τα επτά παιδιά που νοσηλεύονται σε νοσοκομείο της Λιλ, αφού έφαγαν κατεψυγμένα μπιφτέκια βοδινού και υπέστησαν τροφική δηλητηρίαση από το βακτήριο.
Το παιδί υποβλήθηκε σε αιμοκάθαρση, όπως δήλωσε ο καθηγητής Στεφάν Λετέρτρ του νοσοκομείου σε συνέντευξη Τύπου προσθέτοντας ότι χρειάστηκε να καταβληθούν εντατικές προσπάθειες για την ανάνηψή του.Η κατάσταση της υγείας του κρίνεται ανησυχητική, ενώ η προέλευση της μόλυνσης αναμένεται να έχει εντοπιστεί μέχρι αργά τη Δευτέρα.
Σύμφωνα με τον γιατρό το παιδί είχε "τα συνηθισμένα συμπτώματα" της μόλυνσης όμως επιπλέον παρουσίασε "μία νευρολογική κρίση" με αποτέλεσμα να έχει λιποθυμίες.
Η κατάσταση των έξι άλλων παιδιών, ηλικίας 18 μηνών με 8 ετών από διαφορετικές πόλεις της βόρειας Γαλλίας που εξακολουθούν να νοσηλεύονται, είναι "σταθερή", σύμφωνα με τον γιατρό Μισέλ Φουλάρ επικεφαλής της νεφροπαιδιατρικής κλινικής του νοσοκομείου της Λιλ. Για δύο από αυτά εξετάζει το ενδεχόμενο να πάρουν εξιτήριο "στις αρχές της επόμενης εβδομάδας".
Εκτός από αυτά τα επτά παιδιά δύο ακόμη "εξετάζονται για να αποδειχθεί αν έχουν μολυνθεί από το ίδιο βακτηρίδιο" E.coli, δήλωσε ο Γάλλος υπουργός Υγείας Ξαβιέ Μπερτράν.
Πρόκειται για "έναν έφηβο" και "ένα παιδί περίπου 10 ετών" που ζουν στη βόρεια Γαλλία, διευκρίνισε ο καθηγητής Λετέρτρ.
Ο Μπερτράν υπενθύμισε πάντως ότι δεν πρόκειται για το ίδιο στέλεχος του βακτηριδίου E.coli που έχει προκαλέσει το θάνατο 38 ανθρώπων στην Γερμανία, αν και το κρέας προέρχεται από αυτή τη χώρα.
πηγή




















Δεν υπάρχουν σχόλια:
Δημοσίευση σχολίου
ΠΡΟΣΟΧΗ: Οι απόψεις των αναρτήσεων δεν ταυτίζονται υποχρεωτικά με τις δικές μας.
Σημείωση: Μόνο ένα μέλος αυτού του ιστολογίου μπορεί να αναρτήσει σχόλιο.